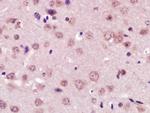
XPC Antibody in Immunohistochemistry (Paraffin) (IHC (P))

Search
Bioss
XPC Polyclonal Antibody
{{$productOrderCtrl.translations['antibody.pdp.commerceCard.promotion.promotions']}}
{{$productOrderCtrl.translations['antibody.pdp.commerceCard.promotion.viewpromo']}}
{{$productOrderCtrl.translations['antibody.pdp.commerceCard.promotion.promocode']}}: {{promo.promoCode}} {{promo.promoTitle}} {{promo.promoDescription}}. {{$productOrderCtrl.translations['antibody.pdp.commerceCard.promotion.learnmore']}}
图: 1 / 4
XPC Antibody (BS-6634R) in IHC (P)

产品信息
BS-6634R
种属反应
宿主/亚型
分类
类型
抗原
偶联物
形式
浓度
规格
纯化类型
保存液
内含物
保存条件
运输条件
靶标信息
This gene encodes a component of the nucleotide excision repair (NER) pathway. There are multiple components involved in the NER pathway, including Xeroderma pigmentosum (XP) A-G and V, Cockayne syndrome (CS) A and B, and trichothiodystrophy (TTD) group A, etc. This component, XPC, plays an important role in the early steps of global genome NER, especially in damage recognition, open complex formation, and repair protein complex formation. Mutations in this gene or some other NER components result in Xeroderma pigmentosum, a rare autosomal recessive disorder characterized by increased sensitivity to sunlight with the development of carcinomas at an early age. Alternatively spliced transcript variants have been found for this gene.
仅用于科研。不用于诊断过程。未经明确授权不得转售。
篇参考文献 (0)
生物信息学
蛋白别名: DNA repair protein complementing XP-C cells; DNA repair protein complementing XP-C cells homolog; mutant xeroderma pigmentosum group C; NER; nucleotide excision repair protein; p125; unnamed protein product; Xeroderma pigmentosum group C-complementing protein; Xeroderma pigmentosum group C-complementing protein homolog; xeroderma pigmentosum, complementation group C
基因别名: p125; RAD4; XP3; XPC; XPCC
UniProt ID: (Human) Q01831, (Mouse) P51612
Entrez Gene ID: (Human) 7508, (Mouse) 22591, (Rat) 312560




